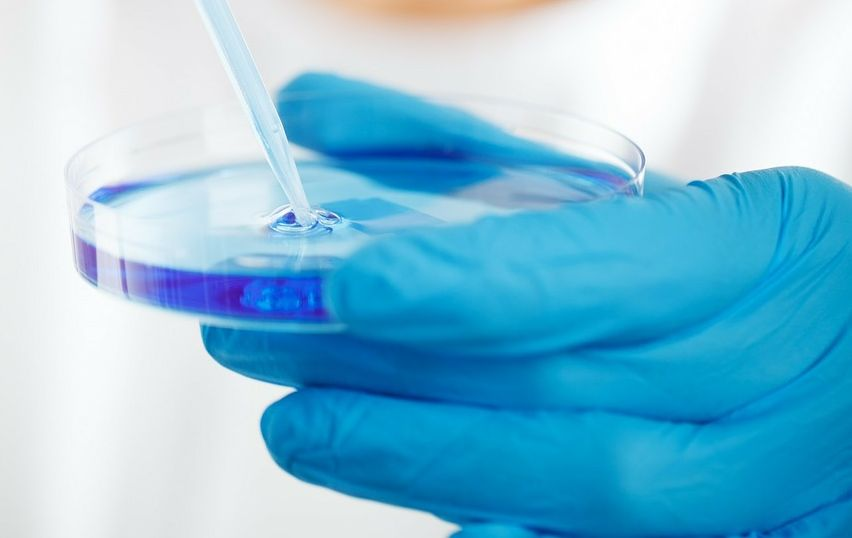

图源startupticker
钛媒体APP注:自2011年以来,瑞士连续13年全球创新指数排名第一,是全球重要的创新策源地,也是中国首个创新战略伙伴关系国,在创新发展和科技金融领域与中国具有极佳互补性。
由Venturelab主办的“瑞士创新100强”,汇聚了最佳“瑞士制造”的初创及成长期科技创新企业,是瑞士最具国际影响力的创新生态标杆。自2011年以来,该榜单每年在瑞士全国范围内评选出100家最具开创性和市场前景的瑞士创新企业和25家最具独角兽潜力的瑞士成长期企业,覆盖生命科学、工程机械、机器人、信息通信、低碳科技、食品科技等领域。
为了全方位展示和介绍瑞士最前沿的创新科技,钛媒体APP与Venturelab的中国授权合作方以明科技(Insight Tech)合作推出《瑞士创新100强》专题,全面展示瑞士先锋科创生态的全景。
本文为专栏第162期,介绍的Numab Therapeutics是2024年《瑞士创新100强》成长期企业,其致力于研发多特异性抗体药物。
瑞士生物科技公司Numab Therapeutics(以下简称Numab)成立于2011年,公司致力于研发多特异性抗体药物。公司拥有专有λ-Cap™和MATCH™抗体发现及工程技术,并基于此开发了用于治疗各类炎症及肿瘤的多特异性抗体药物管线。
Numab由David Urech与Oliver Middendorp共同创立。David Urech为公司首席执行官,拥有巴塞尔生物中心的生物化学博士学位,曾担任ESBATech研发主管,为瑞士生物技术协会董事会成员。Oliver Middendorp为公司董事会成员,拥有巴塞尔大学生物化学博士学位,曾担任ESBATech管理主管。

图源Venturelab
单抗药物局限性逐渐显现,多抗药物疗效更显显著。自1986年强生推出Muromonab-CD3以来,单抗药物在治疗癌症、炎症和自身免疫疾病方面发挥了重要作用。但伴随生物医药不断进步,单抗药物局限性逐渐凸显,特别是在复杂疾病机制面前,单一靶点治疗难以达到理想效果,局限性包括肿瘤微环境复杂性、抗药性问题、免疫激活能力不足以及难以全面阻断多种病理机制等。
为克服单抗药物局限性,多特异性抗体开发成为生物制药领域的重要方向。多特异性抗体能够同时识别并结合多个靶点,增强治疗效果,特别是在癌症治疗过程中,其能提高肿瘤清除率,减少免疫逃逸,有效防止肿瘤复发。


图源Numab Therapeutics
Numab采用专有λ-Cap™和MATCH™核心技术,实现了可重复的多抗疗法设计流程,克服了药物研发过程中的重大障碍。
Numab的λ-Cap™技术能够生成稳定的多特异性抗体。天然的单链抗体稳定性较差,因此单链抗体成药性效果不尽人意。Numab的λ-Cap™抗体技术采用人源化单链抗体片段,具有高效力、稳定性及溶解度,且能以可重复的方式生成高度稳定的多特异性抗体,是多特异性抗体药物的理想构建模块。MATCH™多抗技术全称为Multispecific Antibody-based Therapeutics by Cognate Heterodimerization,是基于同源异二聚体化的多特异性抗体治疗技术,通过将不同的λ-Cap由GS linker连接,基于同源原理组成不同形式的多特异性抗体,可以开发出种类繁多、首创的多特异性抗体疗法。
Numab通过超高通量抗体发现技术,采用人源化单链抗体片段,模块化构建高度稳定的多特异性分子,开发差异化多特异性抗体药物。其技术能有效克服传统抗体、替代支架和单域抗体技术的局限性,快速生成具有可预测稳定性、产量和良好CMC特性的多特异性抗体临床候选药物,且此类药物具有定制的药代动力学特性,在效力、稳定性、疗效持续时间和安全性方面均优于第一代抗体疗法。
基于专有技术,Numab研发了针对炎症与肿瘤的一系列高度差异化的多特异性抗体药物管线,并与多家全球领先制药和生物技术公司建立了强大的研发合作伙伴关系。
在炎症方面,Numab的NM26是靶向IL-4Rα(I型和II型受体)和IL-31的双特异性抗体,用于治疗特应性皮炎和其他2型炎症性疾病,该管线于2024年5月被强生以12.5亿美元收购。Numab的ND081为用于治疗炎症性肠病的同类首创多特异性抗体,目前正与Kaken Pharmaceutical共同合作开发。其同样用于治疗炎症性肠病的抗TNF抗体片段NM09与Mage Biologics合作开发,用于治疗地图样萎缩的ND059则与Boehringer Ingelheim共同开发。
在肿瘤方面,Numab的NM23与ND039均是用于免疫肿瘤学的基于多特异性抗体片段的分子,目前正与Ono Pharmaceutical共同合作开发。ND047是用于治疗胃肠道癌症的T细胞接合器,正与Boehringer Ingelheim合作开发。NM49则是一种多特异性抗体,旨在激活抗肿瘤免疫反应,特别是肿瘤相关的巨噬细胞吞噬作用,正与Ono Pharmaceutical合作开发。
2020年3月,Numab完成了2200万瑞士法郎的B轮融资;2021年5月,Numab完成了1亿瑞士法郎的C轮融资,该轮融资由Novo Holdings和HBM Partners共同领投;2025年1月,Numab完成了5000万瑞士法郎的C轮超额认购,由Cormorant Asset Management领投,C轮融资总额达到1.8亿瑞士法郎,资金将持续用于支持Numab进行同类最佳和同类首创多特异性抗体核心管线产品开发。

2024年《瑞士创新100强》中文版由以明科技(Insight Tech)荣誉发布。以明科技是《瑞士创新100强》的中国授权合作方,负责《瑞士创新100强》在中国的运营推广并协助榜单项目对华商业合作。作为中欧(瑞士)科技创新投资与产业化运营商,以明科技为瑞士创新和中国产业的双向合作提供投融资和商业拓展服务并开展股权投资业务。
获取2024年《瑞士创新100强》完整榜单及行业榜单,请访问以明科技公号或官网。
更多精彩内容,关注钛媒体微信号(ID:taimeiti),或者下载钛媒体App

